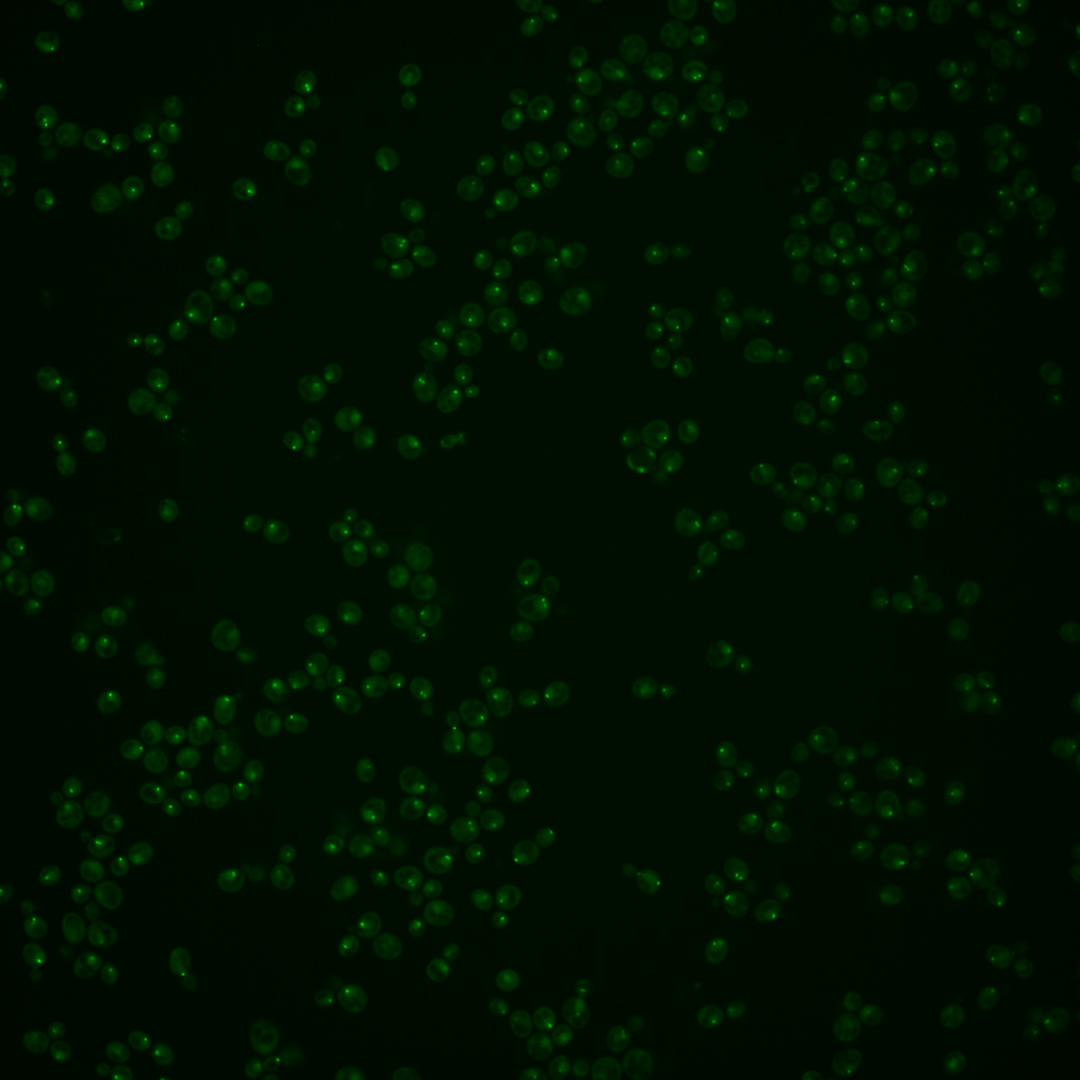
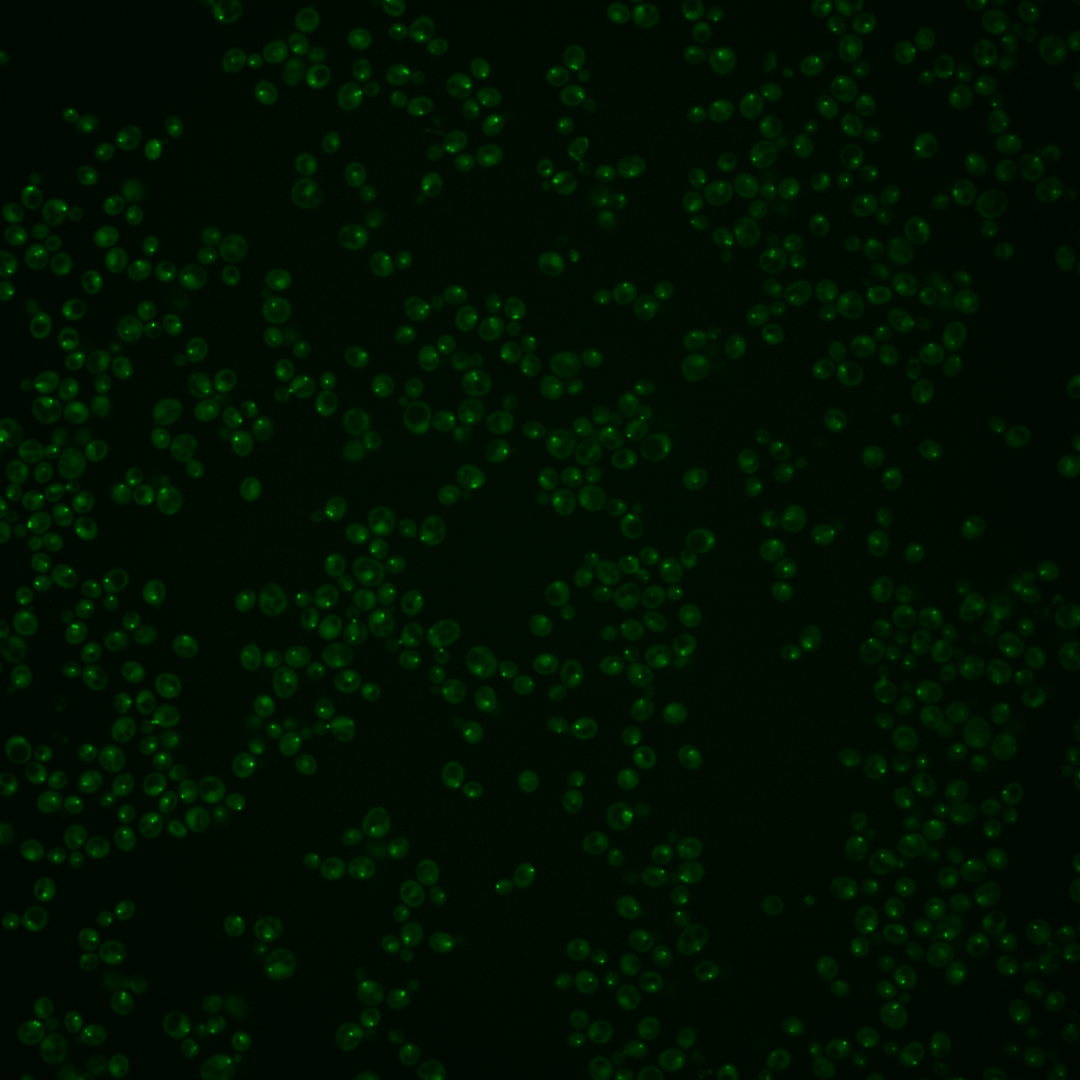
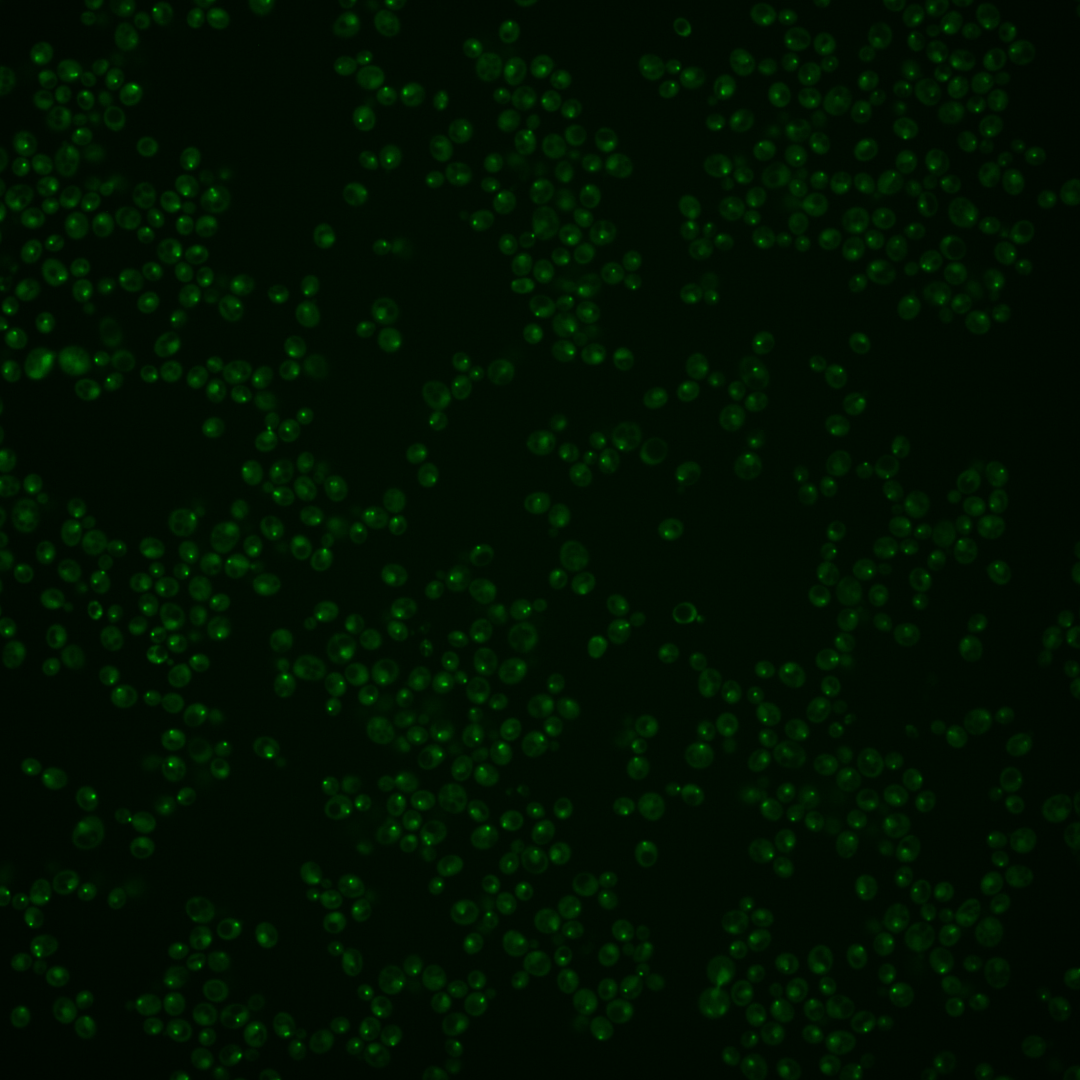
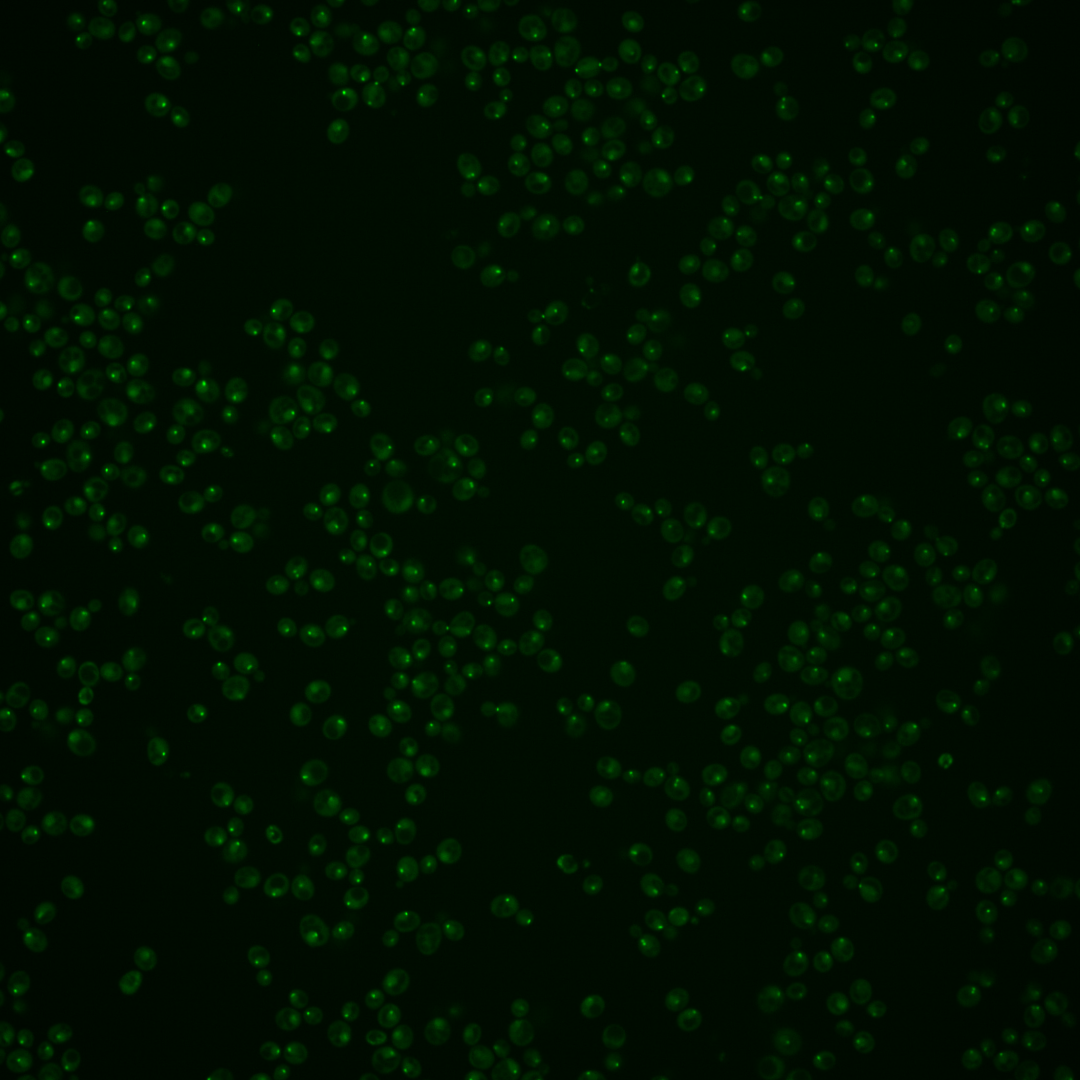

| Standard name | |
|---|---|
| Human Ortholog | |
| Description | Essential kinetochore protein associated with microtubules and SPBs; component of the kinetochore sub-complex COMA (Ctf19p, Okp1p, Mcm21p, Ame1p); involved in spindle checkpoint maintenance; orthologous to human centromere constitutive-associated network (CCAN) subunit CENP-U and fission yeast Mis17; relative distribution to the nucleus increases upon DNA replication stress |
Micrographs




















































































Sub-cellular Localization
Yeast GFP Assignment
Protein Abundance
Localization Change
External localization resources
| ensLOC | DeepLoc | |||||||||||||||||||||||
|---|---|---|---|---|---|---|---|---|---|---|---|---|---|---|---|---|---|---|---|---|---|---|---|---|
| Localization | WT1 | WT2 | WT3 | RAP60 | RAP140 | RAP220 | RAP300 | RAP380 | RAP460 | RAP540 | RAP620 | RAP700 | HU80 | HU120 | HU160 | rpd3Δ_1 | rpd3Δ_2 | rpd3Δ_3 | WT1 | WT2 | WT3 | AF100 | AF140 | AF180 |
| Cortical Patches | 0 | 0 | 1 | 4 | 2 | 1 | 2 | 3 | 2 | 2 | 2 | 2 | 0 | 2 | 1 | 0 | 5 | 3 | 0 | 0 | 0 | 1 | 0 | 4 |
| Bud | 3 | 2 | 3 | 2 | 9 | 4 | 18 | 12 | 18 | 20 | 10 | 7 | 0 | 1 | 1 | 1 | 1 | 2 | 9 | 1 | 1 | 8 | 17 | 25 |
| Bud Neck | 0 | 0 | 4 | 2 | 3 | 2 | 6 | 6 | 8 | 5 | 3 | 3 | 3 | 1 | 1 | 0 | 0 | 0 | 3 | 1 | 0 | 2 | 5 | 15 |
| Bud Site | 3 | 0 | 0 | 6 | 5 | 13 | 19 | 15 | 21 | 18 | 6 | 6 | 0 | 1 | 1 | 1 | 2 | 3 | – | – | – | – | – | – |
| Cell Periphery | 0 | 0 | 0 | 0 | 0 | 0 | 0 | 0 | 0 | 0 | 0 | 0 | 0 | 0 | 0 | 0 | 0 | 0 | 0 | 0 | 0 | 0 | 0 | 0 |
| Cytoplasm | 5 | 5 | 8 | 8 | 25 | 23 | 19 | 14 | 16 | 17 | 8 | 10 | 45 | 125 | 120 | 27 | 35 | 26 | 2 | 1 | 3 | 4 | 8 | 14 |
| Endoplasmic Reticulum | 1 | 0 | 0 | 0 | 0 | 0 | 0 | 0 | 0 | 0 | 0 | 0 | 1 | 1 | 0 | 3 | 7 | 1 | 0 | 0 | 0 | 1 | 1 | 4 |
| Endosome | 93 | 56 | 12 | 32 | 85 | 68 | 42 | 20 | 29 | 42 | 13 | 28 | 90 | 229 | 247 | 112 | 114 | 101 | 31 | 16 | 10 | 26 | 55 | 67 |
| Golgi | 0 | 0 | 0 | 0 | 1 | 0 | 0 | 0 | 0 | 0 | 0 | 0 | 0 | 1 | 0 | 1 | 3 | 2 | 1 | 0 | 0 | 1 | 2 | 4 |
| Mitochondria | 34 | 6 | 1 | 4 | 5 | 17 | 45 | 20 | 61 | 54 | 61 | 25 | 0 | 0 | 0 | 13 | 13 | 10 | 1 | 0 | 0 | 2 | 4 | 7 |
| Nucleus | 18 | 3 | 2 | 13 | 26 | 12 | 15 | 8 | 18 | 12 | 8 | 10 | 21 | 47 | 32 | 7 | 6 | 6 | 9 | 7 | 2 | 18 | 23 | 33 |
| Nuclear Periphery | 1 | 0 | 0 | 1 | 0 | 1 | 0 | 2 | 0 | 0 | 0 | 0 | 1 | 0 | 0 | 1 | 0 | 0 | 1 | 1 | 0 | 1 | 0 | 3 |
| Nucleolus | 232 | 79 | 88 | 87 | 188 | 149 | 164 | 106 | 149 | 137 | 91 | 84 | 100 | 142 | 118 | 113 | 143 | 105 | 10 | 3 | 2 | 9 | 14 | 26 |
| Peroxisomes | 6 | 1 | 0 | 1 | 10 | 8 | 5 | 1 | 4 | 6 | 2 | 4 | 0 | 0 | 13 | 2 | 4 | 1 | 1 | 0 | 0 | 0 | 0 | 2 |
| SpindlePole | 176 | 49 | 139 | 162 | 366 | 254 | 240 | 175 | 177 | 241 | 92 | 121 | 187 | 328 | 248 | 131 | 163 | 136 | 274 | 119 | 172 | 209 | 251 | 327 |
| Vac/Vac Membrane | 13 | 13 | 5 | 5 | 9 | 2 | 7 | 2 | 4 | 5 | 5 | 5 | 13 | 25 | 32 | 28 | 38 | 20 | 4 | 2 | 2 | 6 | 12 | 18 |
| Unique Cell Count | 329 | 122 | 162 | 211 | 459 | 347 | 358 | 253 | 317 | 359 | 188 | 188 | 312 | 620 | 531 | 238 | 303 | 243 | 355 | 157 | 202 | 304 | 413 | 581 |
| Labelled Cell Count | 585 | 214 | 263 | 327 | 734 | 554 | 582 | 384 | 507 | 559 | 301 | 305 | 461 | 903 | 814 | 440 | 534 | 416 | 355 | 157 | 202 | 304 | 413 | 581 |
Yeast GFP Assignment
Protein Abundance
| Screen | WT1 | WT2 | WT3 | RAP60 | RAP140 | RAP220 | RAP300 | RAP380 | RAP460 | RAP540 | RAP620 | RAP700 | HU80 | HU120 | HU160 | rpd3Δ_1 | rpd3Δ_2 | rpd3Δ_3 | AF100 | AF140 | AF180 |
|---|---|---|---|---|---|---|---|---|---|---|---|---|---|---|---|---|---|---|---|---|---|
| Mean Cell GFP Intensity (1e-4) | 5.9 | 7.8 | 6.7 | 6.5 | 6.5 | 5.3 | 5.1 | 5.6 | 4.8 | 5.2 | 4.7 | 5.4 | 6.9 | 7.0 | 7.1 | 9.1 | 9.8 | 9.3 | 7.0 | 7.2 | 7.6 |
| Std Deviation (1e-4) | 1.1 | 1.0 | 1.1 | 1.4 | 1.6 | 1.1 | 1.1 | 1.1 | 0.9 | 1.1 | 0.8 | 1.2 | 1.0 | 0.9 | 1.0 | 1.8 | 2.3 | 1.8 | 1.2 | 1.3 | 1.4 |
| Intensity Change (Log2) | – | – | – | -0.05 | -0.04 | -0.34 | -0.39 | -0.27 | -0.48 | -0.37 | -0.5 | -0.32 | 0.03 | 0.07 | 0.08 | 0.43 | 0.54 | 0.47 | 0.05 | 0.11 | 0.18 |
Localization Change
| Localization | RAP60 | RAP140 | RAP220 | RAP300 | RAP380 | RAP460 | RAP540 | RAP620 | RAP700 | HU80 | HU120 | HU160 | rpd3Δ_1 | rpd3Δ_2 | rpd3Δ_3 |
|---|---|---|---|---|---|---|---|---|---|---|---|---|---|---|---|
| Cortical Patches | 0 | 0 | 0 | 0 | 0 | 0 | 0 | 0 | 0 | 0 | 0 | 0 | 0 | 0 | 0 |
| Bud | 0 | 0 | 0 | 1.7 | 1.5 | 0 | 1.9 | 0 | 0 | 0 | 0 | 0 | 0 | 0 | 0 |
| Bud Neck | 0 | 0 | 0 | 0 | 0 | 0 | 0 | 0 | 0 | 0 | 0 | 0 | 0 | 0 | 0 |
| Bud Site | 0 | 0 | 0 | 3.0 | 3.2 | 0 | 2.9 | 0 | 0 | 0 | 0 | 0 | 0 | 0 | 0 |
| Cell Periphery | 0 | 0 | 0 | 0 | 0 | 0 | 0 | 0 | 0 | 0 | 0 | 0 | 0 | 0 | 0 |
| Cytoplasm | -0.5 | 0.2 | 0.7 | 0.2 | 0.3 | 0.1 | -0.1 | -0.3 | 0.2 | 3.1 | 4.6 | 5.1 | 2.2 | 2.3 | 2.0 |
| Endoplasmic Reticulum | 0 | 0 | 0 | 0 | 0 | 0 | 0 | 0 | 0 | 0 | 0 | 0 | 0 | 0 | 0 |
| Endosome | 2.3 | 3.3 | 3.5 | 1.5 | 0.2 | 0 | 1.5 | 0 | 2.2 | 5.4 | 7.2 | 9.0 | 8.4 | 7.0 | 7.5 |
| Golgi | 0 | 0 | 0 | 0 | 0 | 0 | 0 | 0 | 0 | 0 | 0 | 0 | 0 | 0 | 0 |
| Mitochondria | 0 | 0 | 2.4 | 4.4 | 3.3 | 0 | 5.0 | 0 | 4.5 | 0 | 0 | 0 | 2.6 | 0 | 0 |
| Nucleus | 2.4 | 2.3 | 0 | 1.8 | 0 | 2.3 | 0 | 0 | 2.1 | 2.6 | 3.0 | 2.5 | 0 | 0 | 0 |
| Nuclear Periphery | 0 | 0 | 0 | 0 | 0 | 0 | 0 | 0 | 0 | 0 | 0 | 0 | 0 | 0 | 0 |
| Nucleolus | -2.5 | -2.9 | -2.4 | -1.8 | -2.5 | 0 | -3.4 | 0 | -1.8 | -4.7 | -7.8 | -7.8 | -1.3 | -1.5 | -2.2 |
| Peroxisomes | 0 | 0 | 0 | 0 | 0 | 0 | 0 | 0 | 0 | 0 | 0 | 0 | 0 | 0 | 0 |
| SpindlePole | -2.2 | -1.7 | -3.2 | -4.5 | -3.9 | 0 | -4.4 | 0 | -4.6 | -5.8 | -7.6 | -8.8 | -6.4 | -6.9 | -6.3 |
| Vacuole | 0 | 0 | 0 | 0 | 0 | 0 | 0 | 0 | 0 | 0.6 | 0.6 | 1.5 | 3.1 | 3.4 | 2.1 |
External localization resources
Images






























Protein Concentration and Protein Localization Data
| R1 | R2 | R3 | ||||||||||||||||
|---|---|---|---|---|---|---|---|---|---|---|---|---|---|---|---|---|---|---|
| G1 Pre-START | G1 Post-START | S/G2 | Metaphase | Anaphase | Telophase | G1 Pre-START | G1 Post-START | S/G2 | Metaphase | Anaphase | Telophase | G1 Pre-START | G1 Post-START | S/G2 | Metaphase | Anaphase | Telophase | |
| Concentration | 0.9877 | 1.2203 | 1.1642 | 1.0105 | 0.5937 | 0.9619 | 3.1946 | 2.6688 | 3.4923 | 2.7482 | 2.0176 | 2.835 | 2.531 | 2.1064 | 1.8859 | 2.2206 | 2.42 | 2.322 |
| Actin | 0.0126 | 0.0004 | 0.0001 | 0.0001 | 0.0001 | 0 | 0 | 0 | 0 | 0 | 0 | 0 | 0.0124 | 0.0001 | 0.0067 | 0.0003 | 0.0019 | 0.0027 |
| Bud | 0.0001 | 0.0011 | 0.0003 | 0.0001 | 0.0002 | 0 | 0 | 0 | 0.0012 | 0 | 0 | 0 | 0.0001 | 0.0009 | 0.0001 | 0 | 0 | 0.0001 |
| Bud Neck | 0.0014 | 0.0028 | 0.0021 | 0.0039 | 0.0171 | 0.0021 | 0.0002 | 0.0011 | 0.0006 | 0.0014 | 0.0004 | 0.0004 | 0.0015 | 0.0019 | 0.0071 | 0.0005 | 0.0009 | 0.0013 |
| Bud Periphery | 0.0001 | 0.0004 | 0.0002 | 0 | 0.0002 | 0 | 0 | 0 | 0.0001 | 0 | 0 | 0 | 0.0001 | 0.0002 | 0.0001 | 0 | 0.0001 | 0.0001 |
| Bud Site | 0.0012 | 0.0132 | 0.0018 | 0.0008 | 0.0028 | 0.0002 | 0.0001 | 0.0008 | 0.0011 | 0.0001 | 0 | 0 | 0.0005 | 0.0039 | 0.0033 | 0.0001 | 0.0002 | 0.0003 |
| Cell Periphery | 0 | 0.0001 | 0 | 0 | 0.0001 | 0 | 0 | 0 | 0 | 0 | 0 | 0 | 0 | 0 | 0 | 0 | 0 | 0 |
| Cytoplasm | 0.0023 | 0.0105 | 0.0008 | 0.0005 | 0.0005 | 0.0015 | 0.0021 | 0.0013 | 0.0011 | 0.0001 | 0 | 0.0002 | 0.0009 | 0.0064 | 0.0006 | 0.0018 | 0.0135 | 0.0092 |
| Cytoplasmic Foci | 0.0299 | 0.0111 | 0.0058 | 0.069 | 0.1353 | 0.0084 | 0.0017 | 0.0033 | 0.0018 | 0.0449 | 0.0091 | 0.0036 | 0.0189 | 0.009 | 0.0104 | 0.032 | 0.111 | 0.0156 |
| Eisosomes | 0 | 0 | 0 | 0 | 0 | 0 | 0 | 0 | 0 | 0 | 0 | 0 | 0.0001 | 0 | 0.0001 | 0 | 0 | 0 |
| Endoplasmic Reticulum | 0.0001 | 0.0009 | 0.0001 | 0 | 0 | 0 | 0.0001 | 0 | 0 | 0 | 0 | 0 | 0.0006 | 0.0001 | 0.0001 | 0.0001 | 0.0016 | 0.0008 |
| Endosome | 0.0065 | 0.0077 | 0.001 | 0.013 | 0.01 | 0.0006 | 0.0004 | 0.0007 | 0.0001 | 0.0006 | 0.0001 | 0.0001 | 0.003 | 0.0014 | 0.0013 | 0.0008 | 0.0117 | 0.0027 |
| Golgi | 0.0008 | 0.0008 | 0.0004 | 0.0034 | 0.0036 | 0.0003 | 0.0001 | 0.0001 | 0.0001 | 0.0004 | 0.0002 | 0.0001 | 0.0012 | 0.0004 | 0.0009 | 0.0004 | 0.0034 | 0.0004 |
| Lipid Particles | 0.008 | 0.0041 | 0.0036 | 0.0232 | 0.0156 | 0.0024 | 0.0002 | 0.0001 | 0.0002 | 0.001 | 0.0024 | 0.0004 | 0.0019 | 0.0013 | 0.0029 | 0.0007 | 0.0168 | 0.0009 |
| Mitochondria | 0.0001 | 0.0002 | 0.0003 | 0.0001 | 0.0001 | 0 | 0 | 0 | 0.0001 | 0 | 0 | 0 | 0.0003 | 0.0004 | 0.0097 | 0.0001 | 0.0001 | 0.0003 |
| None | 0.0005 | 0.0022 | 0.0004 | 0.0002 | 0.0002 | 0.0009 | 0.0001 | 0.0003 | 0.0011 | 0.0001 | 0 | 0 | 0.0005 | 0.0006 | 0.0006 | 0.0009 | 0.0168 | 0.0013 |
| Nuclear Periphery | 0.0063 | 0.0052 | 0.0011 | 0.0017 | 0.0003 | 0.0009 | 0.0005 | 0.0022 | 0.0002 | 0.0003 | 0.0001 | 0.0002 | 0.0097 | 0.0022 | 0.0007 | 0.0025 | 0.0027 | 0.0025 |
| Nucleolus | 0.0385 | 0.0569 | 0.061 | 0.0252 | 0.071 | 0.037 | 0.0074 | 0.044 | 0.034 | 0.0014 | 0.0211 | 0.0092 | 0.018 | 0.037 | 0.024 | 0.0029 | 0.0021 | 0.0125 |
| Nucleus | 0.0701 | 0.1804 | 0.0783 | 0.1647 | 0.0097 | 0.0225 | 0.026 | 0.0804 | 0.031 | 0.001 | 0.0017 | 0.0094 | 0.0171 | 0.1003 | 0.0391 | 0.0253 | 0.0013 | 0.0363 |
| Peroxisomes | 0.0009 | 0.0008 | 0.0013 | 0.0064 | 0.0097 | 0.0005 | 0 | 0.0001 | 0.0001 | 0.0026 | 0.0005 | 0.0003 | 0.0008 | 0.0008 | 0.0012 | 0.0027 | 0.0098 | 0.0012 |
| Punctate Nuclear | 0.8185 | 0.6977 | 0.8406 | 0.6857 | 0.7223 | 0.9225 | 0.9611 | 0.8653 | 0.9271 | 0.9461 | 0.9643 | 0.976 | 0.9119 | 0.8324 | 0.8907 | 0.9287 | 0.8056 | 0.9113 |
| Vacuole | 0.0016 | 0.003 | 0.0004 | 0.0017 | 0.0013 | 0.0001 | 0.0001 | 0.0001 | 0.0001 | 0 | 0 | 0 | 0.0002 | 0.0006 | 0.0002 | 0.0001 | 0.0004 | 0.0005 |
| Vacuole Periphery | 0.0002 | 0.0003 | 0.0001 | 0.0001 | 0.0001 | 0 | 0 | 0 | 0 | 0 | 0 | 0 | 0.0002 | 0.0001 | 0.0002 | 0 | 0.0001 | 0.0002 |
Sequencing Data
| R1 | R2 | |||||||||
|---|---|---|---|---|---|---|---|---|---|---|
| G1 Post-START | S/G2 | Metaphase | Anaphase | Telophase | G1 Post-START | S/G2 | Metaphase | Anaphase | Telophase | |
| Gene Expression | 6.7902 | 12.14 | 6.0056 | 11.7941 | 8.0701 | 3.3932 | 13.5534 | 13.4625 | 9.0094 | 11.0707 |
| Translational Efficiency | 1.5407 | 0.8259 | 1.6164 | 0.9952 | 1.2686 | 3.8424 | 0.9856 | 1.0657 | 1.5312 | 1.2318 |
Hit Data
| Dataset | Hit |
|---|---|
| Protein Concentration | ✘ |
| Protein Localization | ✘ |
| Gene Expression | ✘ |
| Translational Efficiency | ✘ |
Endocytosis
| Temp | Actin Patch (Sac6-tdTomato) | Cortical Patch (Sla1-GFP) | Late Endosome (Snf7-GFP) | Vacuole (Vph1-GFP) |
|---|---|---|---|---|
| 37℃ | ||||
| RT |
Cell Cycle Omics
CYCLoPs (Ame1-GFP)
| Gene / Allele | Actin Patch (Sac6-tdTomato) | Cortical Patch (Sla1-GFP) | Late Endosome (Snf7-GFP) | Vacuole (Sac6-tdTomato) |
|---|
| Gene | Images |
|---|
| Gene | Images |
|---|
Images are not yet available
Images are not yet available